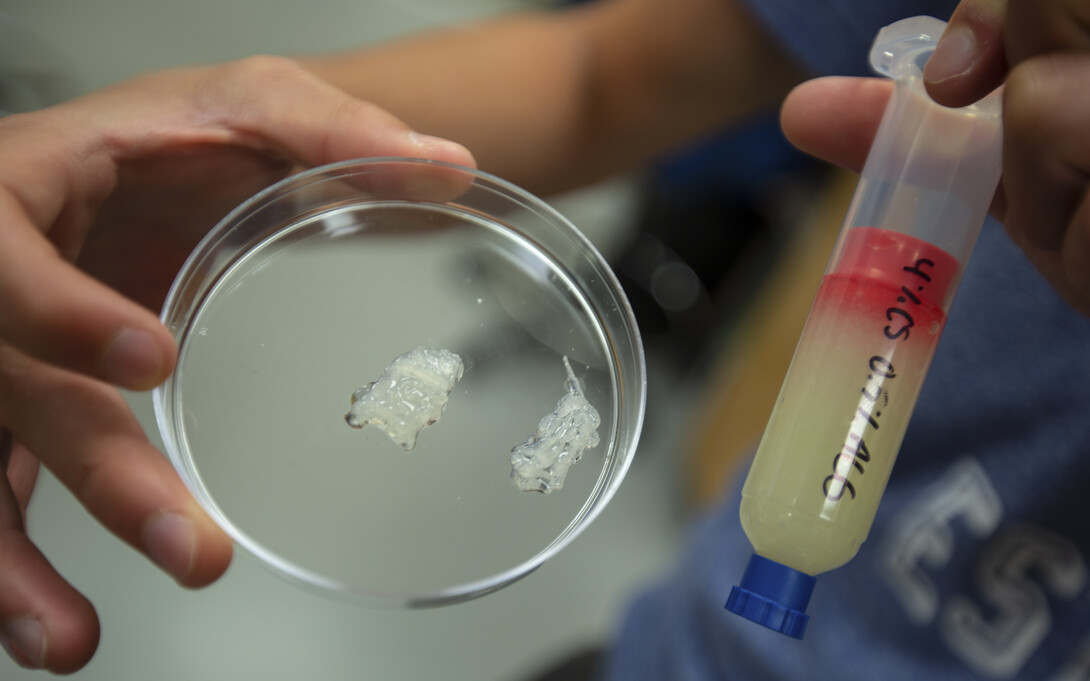

A trauma victim is wheeled into an emergency room, his thigh caked with blood-soaked bandages.
Doctors work quickly to assess the wound — a large, deep laceration; numerous puncture points; flesh missing; bone broken. Definitely a bite, most likely from a shark as reported by the paramedics who transported the young surfer from the beach.

A nurse responds with a specialized scanner that is designed to map the wound, generating digital models of the missing muscle, bone, capillaries, sinew and skin. She forwards the scans to the hospital’s 3-D bio printing lab and — as the surfer is prepared for surgery — a technician generates the tissue that will be used to close the wound.
While science fiction today, University of Nebraska–Lincoln researchers — including Ali Tamayol and Prahalada Rao — are striving to make this scenario a reality.
“Today, if you lose a leg, shatter a knee or break a bone, we can print custom replacement implants,” said Rao, assistant professor of mechanical and materials engineering. “But, to replace functional tissue around those structures is still something that only happens on Star Trek.
“I do think it’s an achievable process. It is just going to take time.”

Rao and Tamayol are approaching the problem from different angles.
Rao, a recent winner of a National Science Foundation CAREER award, is working to perfect the 3-D printing process. He is focused on creating new 3-D printing methods that generate flawless parts — from replacement knees to airplane turbines — every time.

Tamayol, an assistant professor of mechanical and materials engineering, is researching ways to craft bio-inks — 3-D-printed mixtures of cells and gel that can be used to create regenerative tissue implants.
Working with researchers at MIT and Massachusetts General Hospital, Tamayol was part of a team that recently showed how bio-ink infused with platelet-rich plasma can accelerate healing of small scratches.

“The ultimate goal is to generate functional tissue that can be implanted to replace or repair damaged tissues,” said Tamayol. “While we have shown some progress, we still face a number of biological hurdles in the field of tissue engineering.”
Many hurdles center on creating necessary functions within the tissue itself — from establishing the flow of oxygen and nutrients through microscopic capillaries to linking nerves that allow muscle fiber to respond. Plus, the creation of replacement tissue must be completed quickly as it dies in less than 30 minutes unless blood flow is established.
And, while their work may lead to processes that can quickly and reliably create replacement tissues, there remains the issue of rejection by the body.
“Developing techniques to stop the immune response to new biological material introduced into the body is key as we move forward,” Tamayol said. “We also need to examine biological factors that can engage cells from the host body to regenerate tissue.”
A possible solution to reduce the immune response is to mix a patient’s own cells and platelets into bio-inks — a process that showed promise in Tamayol’s recent study.
Based on the pace of advancement within the industry, Tamayol and Rao estimate that engineered replacement tissues will become a reality within the next decade.
Husker-led research in 3-D printing is supported by the Nebraska Engineering Additive Technology, or NEAT, Labs. The space, located in the Scott Engineering Center, features four cutting-edge printers that can add or subtract a variety of materials. Nebraska Engineering also has a state-of-the-art bio-printer, with a second one going online later this year.
“Ten years ago, there was no way we could print an engine. Last year, Space X released the SuperDraco, a 3-D printed rocket engine,” Rao said. “Innovation in this field is moving very quickly. And, through investments made in equipment and new partnerships being formed with industry and colleagues around the world, Nebraska is poised to be a leader in the future of 3-D printing.”







